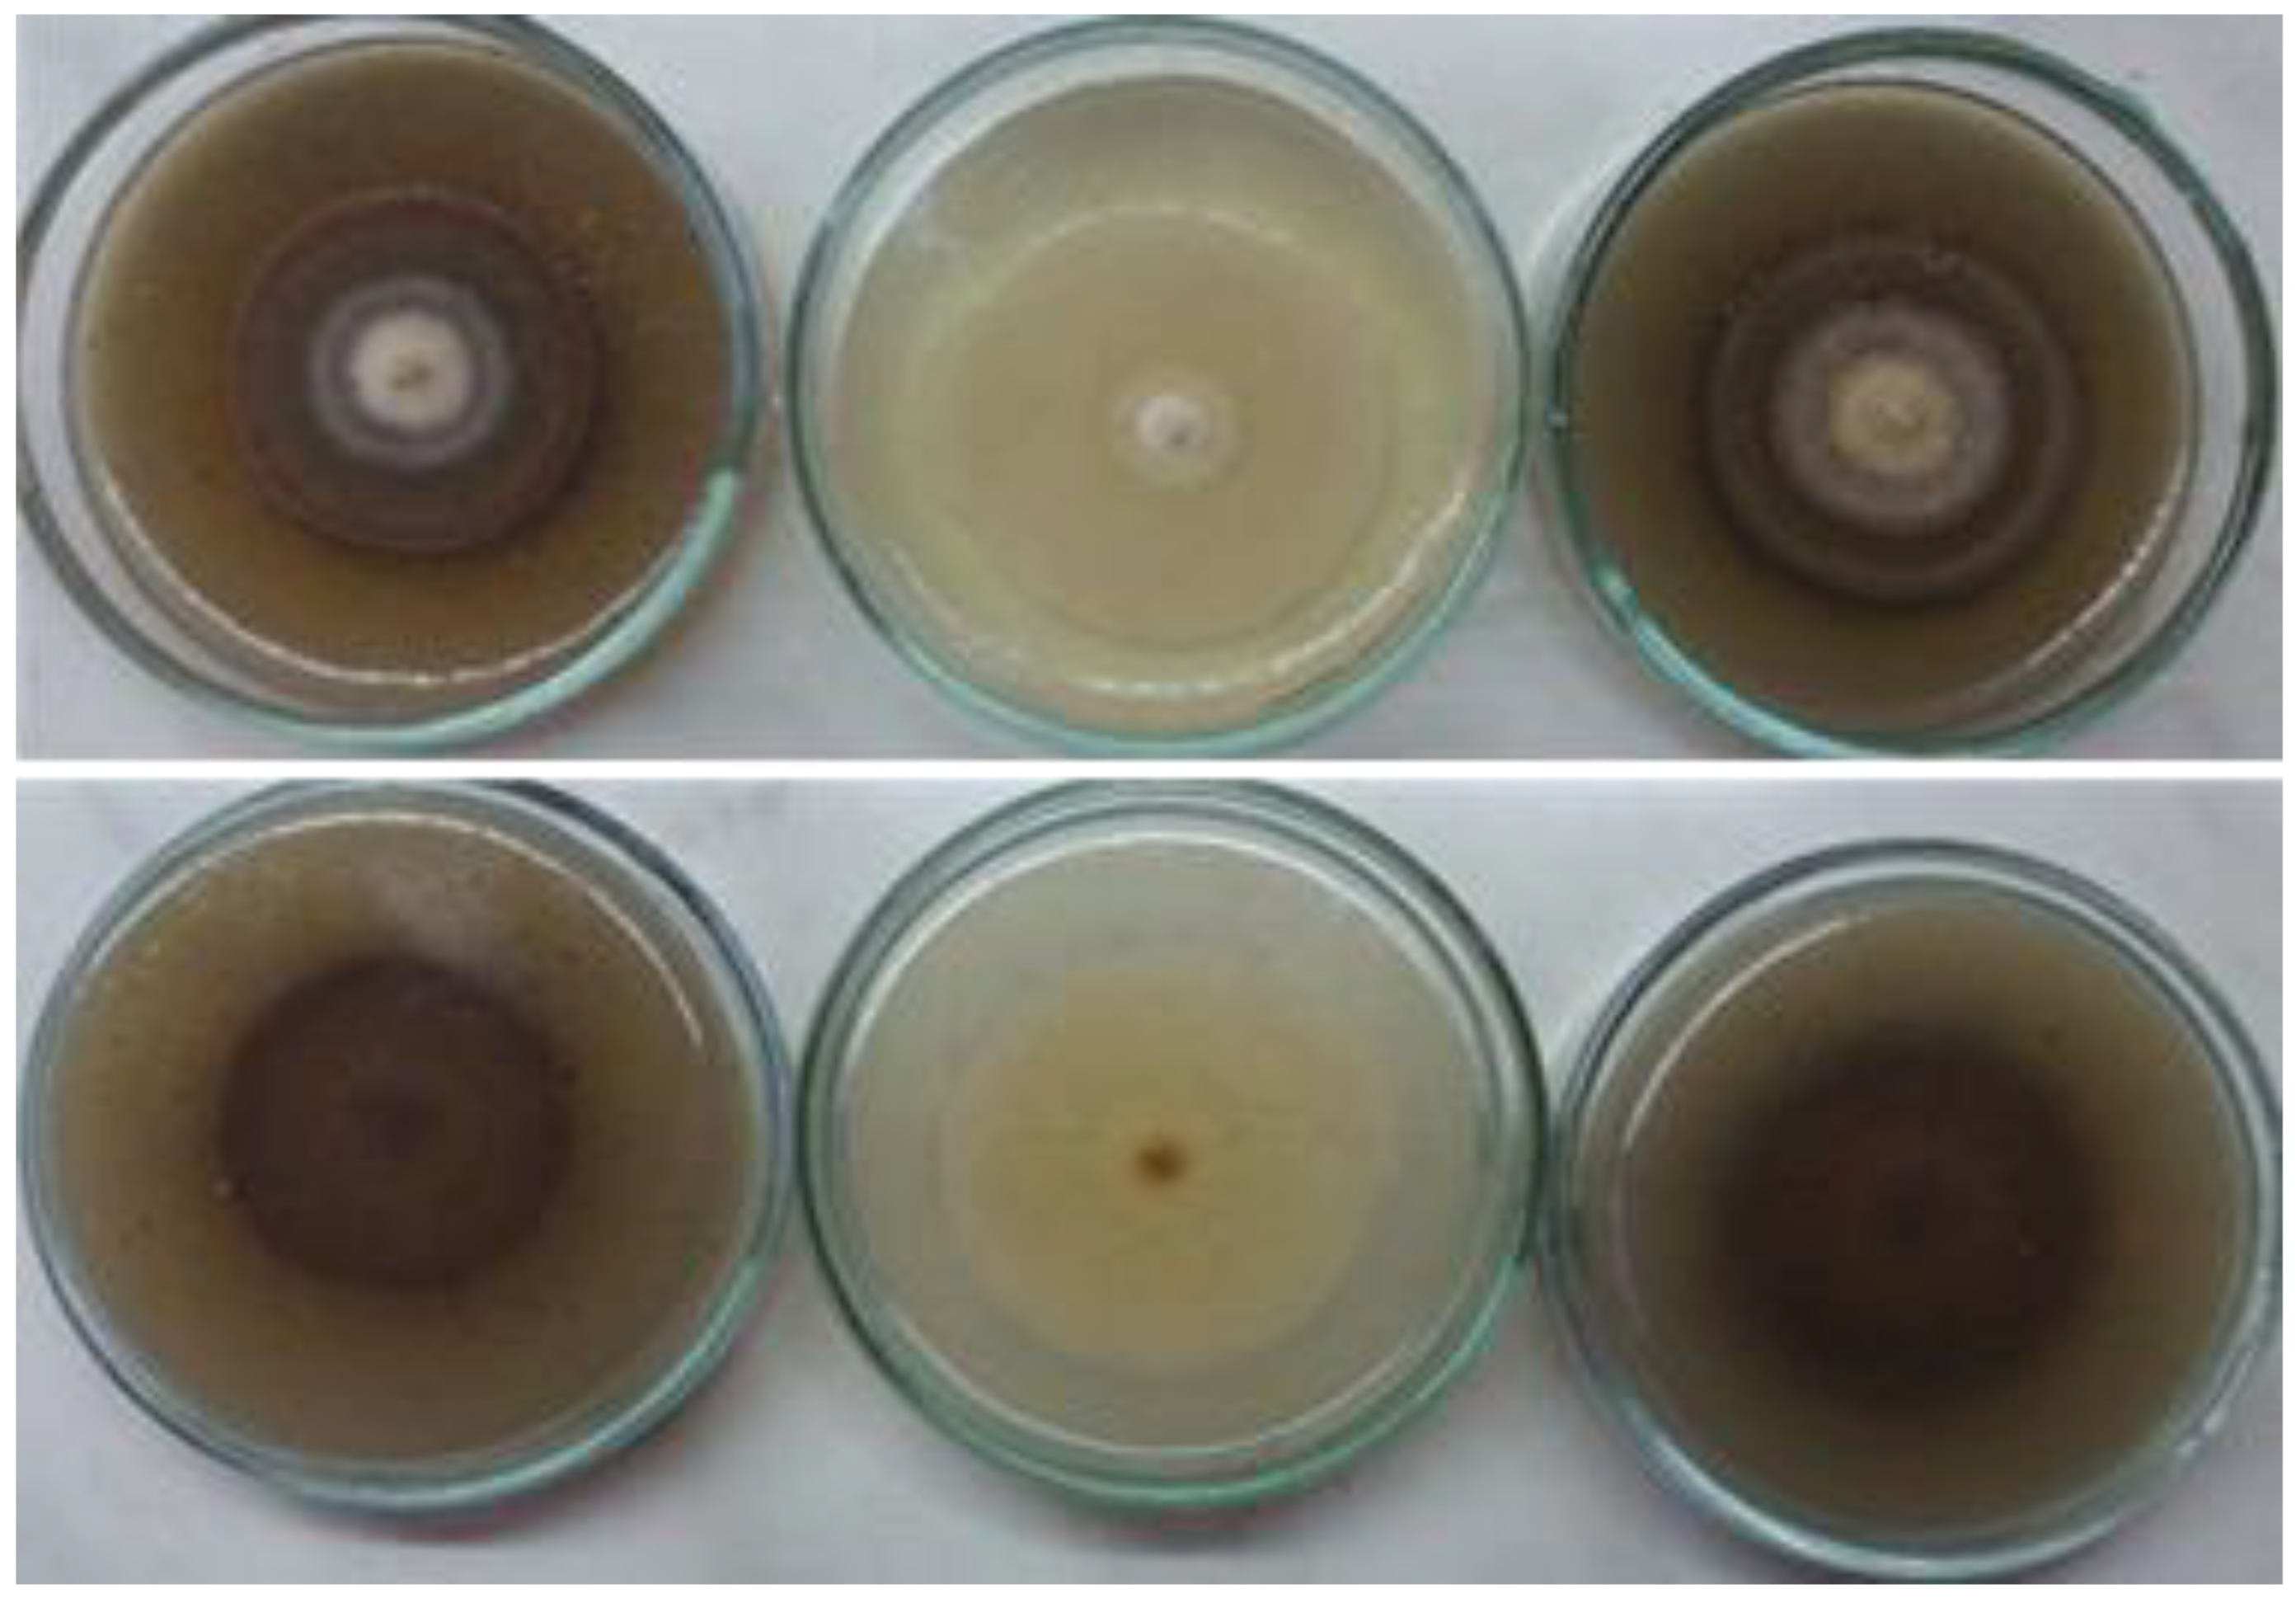
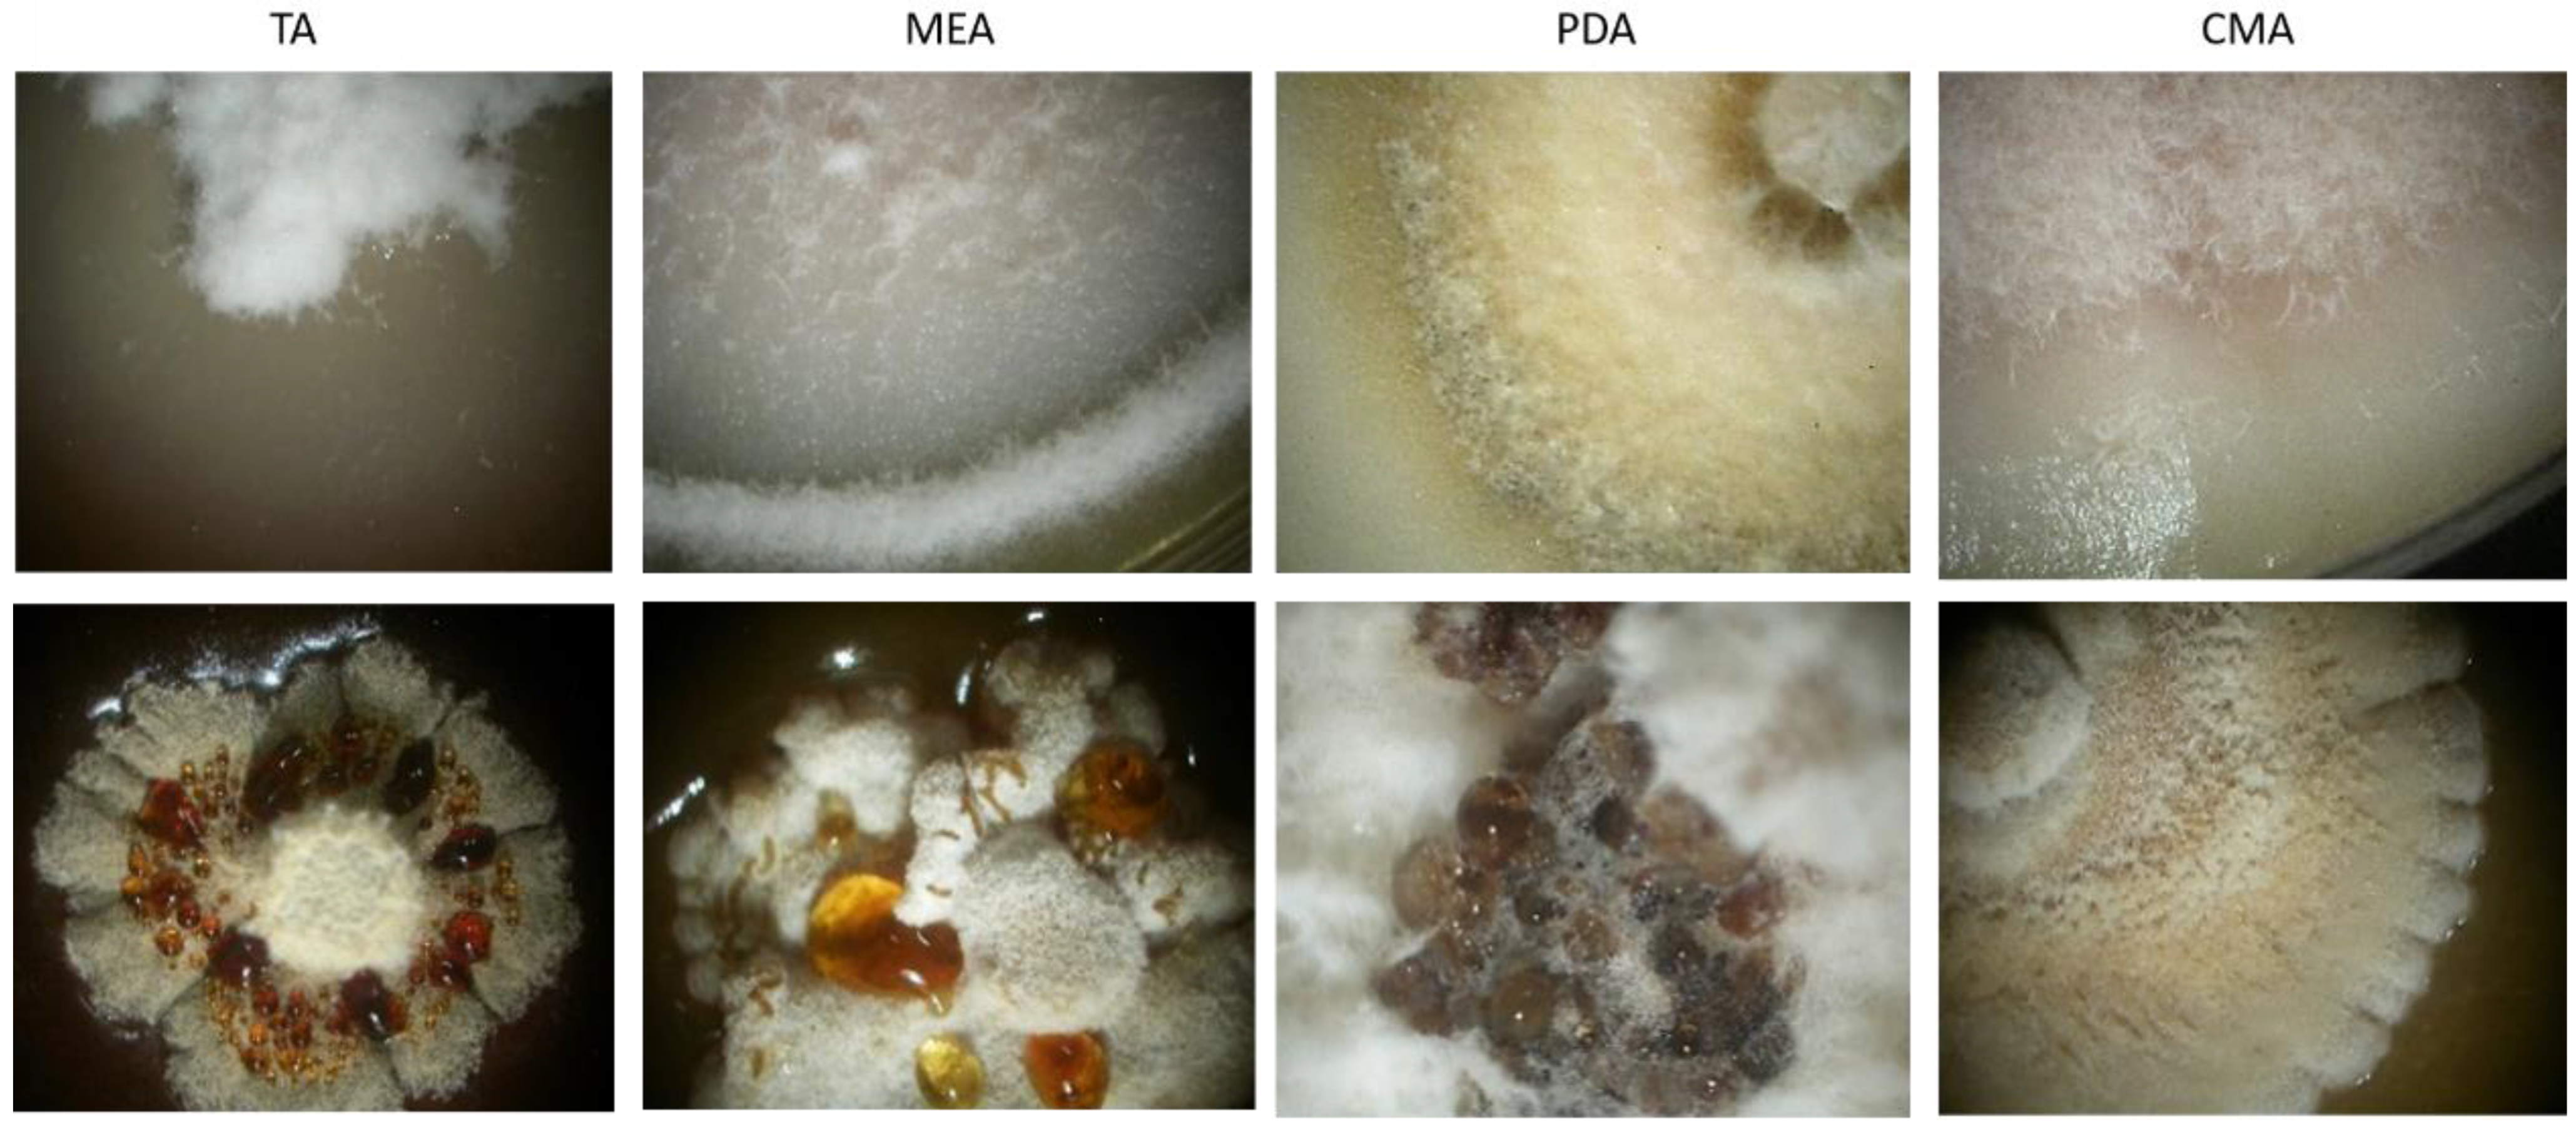

Morphological, Molecular, and Pathogenic Characterization of Neofabraea alba, a Postharvest Pathogen of Apple in Serbia
Abstract
1. Introduction
2. Materials and Methods
2.1. Collection and Storage of Isolates
2.2. Pathogenicity Test
2.3. Morphological Characterization
2.4. Physiological Characterization
2.5. DNA Extraction, Amplification, Sequencing and Analysis
2.6. Statistical Analyses
3. Results
3.1. Collection of Isolates
3.2. Pathogenicity Test
3.3. Morphological Characterization
3.4. Physiological Characterization
3.5. Molecular Identification and Characterization
4. Discussion
Author Contributions
Funding
Data Availability Statement
Conflicts of Interest
References
- Maxin, P.; Weber, R.W.; Pedersen, H.L.; Williams, M. Control of a wide range of storage rots in naturally infected apples by hot-water dipping and rinsing. Postharvest Biol. Technol. 2012, 70, 25–31. [Google Scholar] [CrossRef]
- Köhl, J.; Wenneker, M.; Haas, B.H.G.-D.; Anbergen, R.; de Geijn, H.M.G.-V.; der Plas, C.H.L.-V.; Pinto, F.A.M.F.; Kastelein, P. Dynamics of post-harvest pathogens Neofabraea spp. and Cadophora spp. in plant residues in Dutch apple and pear orchards. Plant Pathol. 2018, 67, 1264–1277. [Google Scholar] [CrossRef]
- Wenneker, M.; Pham, K.T.K.; Boekhoudt, L.C.; De Boer, F.A.; Van Leeuwen, P.J.; Hollinger, T.C.; Thomma, B.P.H.J. First Report of Neofabraea kienholzii Causing Bull’s Eye Rot on Pear (Pyrus communis) in the Netherlands. Plant Dis. 2017, 101, 634. [Google Scholar] [CrossRef]
- Bogo, A.; Comparin, C.; Valdebenito-Sanhueza, R.; Ritschel, P.; Casa, R.; Da Silva, F.; Everhart, S. Characterization of Neofabraea actinidiae and N. brasiliensis as causal agents of apple bull’s-eye rot in southern Brazil. Can. J. Plant Pathol. 2018, 40, 229–237. [Google Scholar] [CrossRef]
- Soto-Alvear, S.; Lolas, M.; Rosales, I.M.; Chávez, E.R.; Lattore, B.A. Characterization of the bull’s eye rot of apple in Chile. Plant Dis. 2013, 97, 485–490. [Google Scholar] [CrossRef] [PubMed]
- Michalecka, M.; Bryk, H.; Poniatowska, A.; Pulawska, J. Identification of Neofabraea species causing bull’s eye rot of apple in Poland and their direct detection in apple fruit using multiplex PCR. Plant Pathol. 2016, 65, 643–654. [Google Scholar]
- Pešicová, K.; Kolarik, M.; Hortová, B.; Novotny, D. Diversity and identification of Neofabraea species causing bull’s eye rot in the Czech Republic. Eur. J. Plant Pathol. 2017, 147, 683–693. [Google Scholar] [CrossRef]
- Romero, J.; Raya, M.C.; Roca, L.F.; Moral, J.; Trapero, A. First Report of Neofabraea vagabunda Causing Branch Cankers on Olives in Spain. Plant Dis. 2016, 100, 527. [Google Scholar]
- Vico, I.; Duduk, N.; Vasić, M.; Zebeljan, A.; Radivojević, D. Bull’s eye rot of apple fruit caused by Neofabraea alba. Acta Hortic. 2016, 1139, 733–738. [Google Scholar] [CrossRef]
- Krsmanović, S.; Grahovac, M.; Medić, J.; Stojšin, V.; Petreš, M. Struktura populacije prouzrokovača truleži uskladištenih plodova jabuke. Plant Dr. 2018, 46, 563–569. [Google Scholar]
- Petreš, M.; Kalajdžić, J.; Milić, B.; Magazin, N.; Stankov, A.; Vukotić, J.; Grahovac, M. Effect of hot water treatments on apple fruit rot caused by Fusarium spp. J. Plant Dis. Prot. 2020, 127, 651–655. [Google Scholar] [CrossRef]
- Spotts, R.A.; Seifert, K.A.; Wallis, K.M.; Sugar, D.; Xiao, C.L.; Serdani, M.; Henriquez, J.L. Description of Cryptosporiopsis kienholzii and species profiles of Neofabraea in major pome fruit growing districts in the Pacific Northwest USA. Mycol. Res. 2009, 113, 1301–1311. [Google Scholar] [CrossRef]
- Gariepy, T.D.; Rahe, J.E.; Lèvesque, C.A.; Spotts, R.A.; Sugar, D.L.; Henriquez, J.L. Neofabraea species associated with bull’s eye rot and canker of apple and pear in the Pacific Northwest. Can. J. Plant Pathol. 2005, 27, 118–124. [Google Scholar] [CrossRef]
- Abeln, E.C.A.; Pagter, M.A.; Verkley, G.J.M. Phylogeny of Pezicula, Dermea and Neofabraea inferred from partial sequences of the nuclear ribosomal RNA gene cluster. Mycologia 2000, 92, 685–693. [Google Scholar] [CrossRef]
- de Jong, S.N.; Lèvesque, C.A.; Verkley, G.J.M.; Abeln, E.C.A.; Rahe, J.E.; Braun, P.G. Phylogenetic relationships among Neofabraea species causing tree cankers and bull’s eye rot of apple based on DNA sequencing of ITS nuclear rDNA, mitochondrial rDNA, and β-tubulin gene. Mycol. Res. 2001, 105, 658–669. [Google Scholar] [CrossRef]
- de Jong, S.N. The Development of Specific, Non-Discriminating PCR Primers for the Detection of Pezicula malicorticis and P. perennans Agents of Anthracnose Canker, Perennial Canker, and Bull’s-Eye Rot of Apple. Master’s Thesis, Department of Biological Sciences, Simon Fraser University, Burnaby, BC, Canada, 1998. [Google Scholar]
- Gariepy, T.D.; Levesque, C.A.; de Jong, S.N.; Rahe, J.E. Species specific identification of the Neofabraea pathogen complex associated with pome fruits using PCR and multiplex DNA amplification. Mycol. Res. 2003, 107, 528–536. [Google Scholar] [CrossRef]
- Henriquez, J.L.; Sugar, D.; Spotts, R.A. Induction of Cankers on Pear Tree Branches by Neofabraea alba and N. perennans, and Fungicide Effects on Conidial Production on Cankers. Plant Dis. 2006, 90, 481–486. [Google Scholar] [CrossRef]
- White, T.J.; Bruns, T.; Lee, T.J. Amplification and direct sequencing of fungal ribosomal RNA genes for phylogenetics. In PCR Protocols, a Guide to Methods and Applications; Innis, M.A., Gelfand, D.H., Sninsky, J.J., White, T.J., Eds.; Academic Press: San Diego, CA, USA, 1990; pp. 315–322. [Google Scholar]
- Boratyn, G.M.; Camacho, C.; Cooper, P.S.; Coulouris, G.; Fong, A.; Ma, N.; Madden, T.L.; Matten, W.T.; McGinnis, S.D.; Marezhuk, Y.; et al. BLAST: A more efficient report with usability improvements. Nucleic Acids Res. 2013, 41, 29–33. [Google Scholar] [CrossRef]
- Kumar, S.; Stecher, G.; Tamura, K. MEGA7: Molecular Evolutionary Genetics Analysis version 7.0 for bigger datasets. Mol. Biol. Evol. 2016, 33, 1870–1874. [Google Scholar] [CrossRef]
- Snowdon, A.L. Pome fruits. In A Colour Atlas of Post-Harvest Diseases and Disorders of Fruits and Vegetables; Snowdon, A.L., Ed.; Wolfe Scientific Ltd.: London, UK, 1990; Volume 1, pp. 170–218. [Google Scholar]
- Carneiro, G.A.; Walcher, M.; Storti, A.; Baric, S. Phylogenetic diversity and Phenotypic characterization of Phlyctema vagabunda (syn. Neofabraea alba) and Neofabraea kienholzii causing postharvest bull’s eye rot of apple in northern Italy. Plant Dis. 2022, 106, 451–463. [Google Scholar] [CrossRef]
- Corke, A.T.K. Bitter rot of apples II. Seasonal variations in the development and sporulation of cankers of Gloeosporium spp. inoculated into apple branches. J. Hortic. Sci. 1956, 31, 272–283. [Google Scholar] [CrossRef]
- Hortova, B.; Novotny, D.; Erban, T. Physiological characteristics and pathogenicity of eight Neofabraea isolates from apples in Czechia. Eur. J. Hortic. Sci. 2014, 79, 327–334. [Google Scholar]
- Cameldi, I.; Neri, F.; Ventrucci, D.; Ceredi, G.; Muzzi, E.; Mari, M. Influence of harvest date on bull’s eye rot of Cripps Pink apples and control chemical strategies. Plant Dis. 2016, 100, 2287–2293. [Google Scholar] [CrossRef]
- Neri, F.; Mari, M.; Brigati, S.; Bertolini, P. Control of Neofabraea alba by plant volatile compounds and hot water. Postharvest Biol. Technol. 2009, 51, 425–430. [Google Scholar] [CrossRef]
- Everett, K.; Pushparajah, I.; Fisher, B.M.; Wood, P. A simple method for conidial production and establishing latent infections of apples by Phlyctema vagabunda (syn: Neofabraea alba). N. Z. Plant Prot. 2017, 70, 106–111. [Google Scholar] [CrossRef][Green Version]
- Cameldi, I.; Neri, F.; Menghini, M.; Pirondi, A.; Nanni, I.M.; Collina, M.; Mari, M. Characterization of Neofabraea vagabunda isolates causing apple bull’s eye rot in Italy (Emilia-Romagna region). Plant Pathol. 2017, 66, 1432–1444. [Google Scholar] [CrossRef]
- Verkley, G.J.M. A monograph of Pezicula and its anamorphs. Stud. Mycol. 1999, 44, 1–176. [Google Scholar]
- Henriquez, J.L. Studies on the Etiology and Epidemiology of Bull’s Eye Rot of Pears. Ph.D. Thesis, Oregon State University, Ann Arbor, MI, USA, 2003. [Google Scholar]
- Rooney-Latham, S.; Gallegos, L.L.; Vossen, P.M.; Gubler, W.D. First report of Neofabraea alba causing fruit spot on olive in North America. Plant Dis. 2013, 97, 1384. [Google Scholar] [CrossRef] [PubMed]
- Trouillas, F.P.; Nouri, M.T.; Lawrence, D.P.; Moral, J.; Travadon, R.; Aegerter, B.J.; Danielle, L. Identification and Characterization of Neofabraea kienholzii and Phlyctema vagabunda Causing Leaf and Shoot Lesions of Olive in California. Plant Dis. 2019, 103, 3018–3030. [Google Scholar] [CrossRef]

| Species | Isolate Number | Source | Location | Host | Reference Number | |
|---|---|---|---|---|---|---|
| ITS | SSU | |||||
| Neofabraea alba | J34/1 | Vukotić | Serbia | Apple | OM761173 | OM514687 |
| Neofabraea alba | J35 | Vukotić | Serbia | Apple | OM491330 | OM514688 |
| Neofabraea alba | J45/2 | Vukotić | Serbia | Apple | OM638703 | OM677770 |
| Neofabraea alba | J50/2 | Vukotić | Serbia | Apple | OM491331 | OM514689 |
| Neofabraea alba | J53/1 | Vukotić | Serbia | Apple | OM638704 | OM677771 |
| Neofabraea alba | J57/2 | Vukotić | Serbia | Apple | OM761173 | OM514690 |
| Neofabraea alba | J59/2 | Vukotić | Serbia | Apple | OL889667 | OM677778 |
| Neofabraea alba | J60 | Vukotić | Serbia | Apple | OM491332 | OM514691 |
| Neofabraea alba | J63 | Vukotić | Serbia | Apple | OM761176 | OM514692 |
| Neofabraea alba | J67/2 | Vukotić | Serbia | Apple | OM491333 | OM514693 |
| Neofabraea alba | J75 | Vukotić | Serbia | Apple | OM491334 | OM514694 |
| Neofabraea alba | J77/2 | Vukotić | Serbia | Apple | OM638707 | OM677776 |
| Neofabraea alba | J87 | Vukotić | Serbia | Apple | OM761177 | OM514695 |
| Neofabraea alba | J108/2 | Vukotić | Serbia | Apple | OM491335 | OM514696 |
| Neofabraea alba | J109/1 | Vukotić | Serbia | Apple | OM63870 | OM677772 |
| Neofabraea alba | J129 | Vukotić | Serbia | Apple | OM761180 | OM677773 |
| Neofabraea alba | J148 | Vukotić | Serbia | Apple | OM761181 | OM514697 |
| Neofabraea alba | J151 | Vukotić | Serbia | Apple | OM761182 | OM677774 |
| Neofabraea alba | J202 | Vukotić | Serbia | Apple | OM761184 | OM677775 |
| Neofabraea alba | ATCC 38338 | De Jong | Poland | Apple | AF281366 | AF281404 |
| Neofabraea alba | M822 | Romero | Italy | Apple | KT454381 | KT963895 |
| Neofabraea alba | CBS 452.64 | Abeln | UK | Canada | AF141190 | AF281448 |
| Neofabraea alba | CAL 135 | De Jong | Canada | Apple | AF281372 | AF281419 |
| Neofabraea alba | DAOM 227091 | De Jong | Canada | Apple | AF281368 | AF281436 |
| Neofabraea alba | OGT3 | Carneiro | Italy | Apple | MW130163 | MW228886 |
| Neofabraea alba | 19-DSS-FU-1-013 | Carneiro | Italy | Apple | MW130184 | MW228852 |
| Neofabraea malicorticis | CAL 102 | De Jong | Canada | Apple | AF281379 | AF281405 |
| Neofabraea malicorticis | DAOM 227083 | De Jong | Canada | Apple | AF281385 | AF281406 |
| Neofabraea perennans | DAOM 227089 | De Jong | Canada | Apple | AF281392 | AF281432 |
| Neofabraea perennans | RGR 90.0123 | De Jong | USA | Apple | AF281396 | AF281449 |
| Neofabraea kienholzii | DAOM 227086 | De Jong | Canada | Apple | AF281398 | AF281409 |
| Pezicula corticola | CBS 259.31 | Abeln | Denmark | Apple | AF141179 | AF281443 |
| Warehouse Location | Year | Number of Fruits withBull’s Eye Rot-Like Symptoms | Number of Fruits Infected with Neofabraea spp. | Incidence of Neofabraea spp. (%) |
|---|---|---|---|---|
| Tavankut | 2017 | 36 | 19 | 52.8 |
| Jazak | 36 | 3 | 8.3 | |
| Mala Remeta | 20 | 9 | 45.0 | |
| Titel | 20 | 3 | 15.0 | |
| Irig | 22 | 6 | 27.3 | |
| Novi Sad | 29 | 8 | 27.6 | |
| Ljutovo | 15 | 10 | 66.7 | |
| Bački Vinogradi | 17 | 9 | 52.9 | |
| Slankamen | 19 | 12 | 63.2 | |
| Bačka Topola | 10 | 5 | 50.0 | |
| Subotica | 20 | 10 | 50.0 | |
| Hajdukovo | 15 | 8 | 53.3 | |
| Horgoš | 10 | 1 | 10.0 | |
| Subtotal=13 | 269 | 103 | 38.3 | |
| Tavankut | 2018 | 150 | 107 | 71.3 |
| Jazak | 20 | 2 | 10 | |
| Mala Remeta | 9 | 0 | 0.0 | |
| Titel | 14 | 5 | 35.7 | |
| Kukujevci | 225 | 170 | 75.6 | |
| Subtotal = 5 | 418 | 284 | 67.9 | |
| Total = 18 | 687 | 387 | 56.3 |
| Isolates | Apple Branches | |||
|---|---|---|---|---|
| Length of Canker (mm) a | Visible Acervuli | Size of Conidia (µm) | ||
| Mean (Length × Width) | Range | |||
| J34/1 | 49.3 ± 6.4 b a | Yes | 18.4 × 3.1 | 7.5–25 × 2.5–5 |
| J148 | 19.3 ± 2.1 a | No | 14.2 × 2.7 | 7.5–25 × 2.5–5 |
| J67/2 | 52.0 ± 8.0 bc | Yes | 17.6 × 3.0 | 7.5–27 × 2.5–5 |
| J129 | 14.0 ± 1.0 a | No | 16.8 × 2.9 | 10–26 × 2–5 |
| J151 | 20.0 ± 2.0 a | No | 19.9 × 3.4 | 11–26 × 2.5–5 |
| J96 | 60.0 ± 5.0 c | Yes | 19.5 × 2.6 | 12.5–25 × 2.8–5 |
| Isolate Number | Year of Isolation | Location | Cultivar | Morphotype of Isolates * |
|---|---|---|---|---|
| J34/1 | 2017 | Slankamen | Red chief | I |
| J35/1 | 2017 | Slankamen | Mutsu | I |
| J45/2 | 2017 | Irig | Granny Smith | II |
| J50/2 | 2017 | Irig | Jonagored | II |
| J53/1 | 2017 | Ljutovo | Granny Smith | I |
| J57/2 | 2017 | Ljutovo | Granny Smith | II |
| J59/2 | 2017 | Ljutovo | Granny Smith | I |
| J60 | 2017 | Ljutovo | Granny Smith | I |
| J61/2 | 2017 | Ljutovo | Granny Smith | I |
| J63 | 2017 | Subotica | Pink Lady | I |
| J67/2 | 2017 | Subotica | Idared | I |
| J73/2 | 2017 | Irig | Pink Lady | II |
| J75 | 2017 | Ljutovo | Granny Smith | II |
| J77/2 | 2017 | Subotica | Idared | II |
| J87 | 2017 | Hajdukovo | Idared | I |
| J96/2 | 2017 | Tavankut | Golden delicious | I |
| J105/2 | 2017 | Backi Vinogradi | Idared | I |
| J108/2 | 2017 | Backi Vinogradi | Idared | II |
| J109/1 | 2017 | Backi Vinogradi | Idared | I |
| J117 | 2017 | Backa Topola | Idared | II |
| J129 | 2018 | Tavankut | Golden delicious | I |
| J148 | 2018 | Tavankut | Golden delicious | II |
| J151 | 2018 | Tavankut | Golden delicious | I |
| J189 | 2018 | Kukujevci | Jonagold | II |
| J202 | 2018 | Kukujevci | Jonagold | I |
Publisher’s Note: MDPI stays neutral with regard to jurisdictional claims in published maps and institutional affiliations. |
© 2022 by the authors. Licensee MDPI, Basel, Switzerland. This article is an open access article distributed under the terms and conditions of the Creative Commons Attribution (CC BY) license (https://creativecommons.org/licenses/by/4.0/).
Share and Cite
Vukotić, J.; Stojšin, V.; Nagl, N.; Petreš, M.; Hrustić, J.; Grahovac, M.; Tanović, B. Morphological, Molecular, and Pathogenic Characterization of Neofabraea alba, a Postharvest Pathogen of Apple in Serbia. Agronomy 2022, 12, 2015. https://doi.org/10.3390/agronomy12092015
Vukotić J, Stojšin V, Nagl N, Petreš M, Hrustić J, Grahovac M, Tanović B. Morphological, Molecular, and Pathogenic Characterization of Neofabraea alba, a Postharvest Pathogen of Apple in Serbia. Agronomy. 2022; 12(9):2015. https://doi.org/10.3390/agronomy12092015
Chicago/Turabian StyleVukotić, Jelena, Vera Stojšin, Nevena Nagl, Mladen Petreš, Jovana Hrustić, Mila Grahovac, and Brankica Tanović. 2022. "Morphological, Molecular, and Pathogenic Characterization of Neofabraea alba, a Postharvest Pathogen of Apple in Serbia" Agronomy 12, no. 9: 2015. https://doi.org/10.3390/agronomy12092015
APA StyleVukotić, J., Stojšin, V., Nagl, N., Petreš, M., Hrustić, J., Grahovac, M., & Tanović, B. (2022). Morphological, Molecular, and Pathogenic Characterization of Neofabraea alba, a Postharvest Pathogen of Apple in Serbia. Agronomy, 12(9), 2015. https://doi.org/10.3390/agronomy12092015

